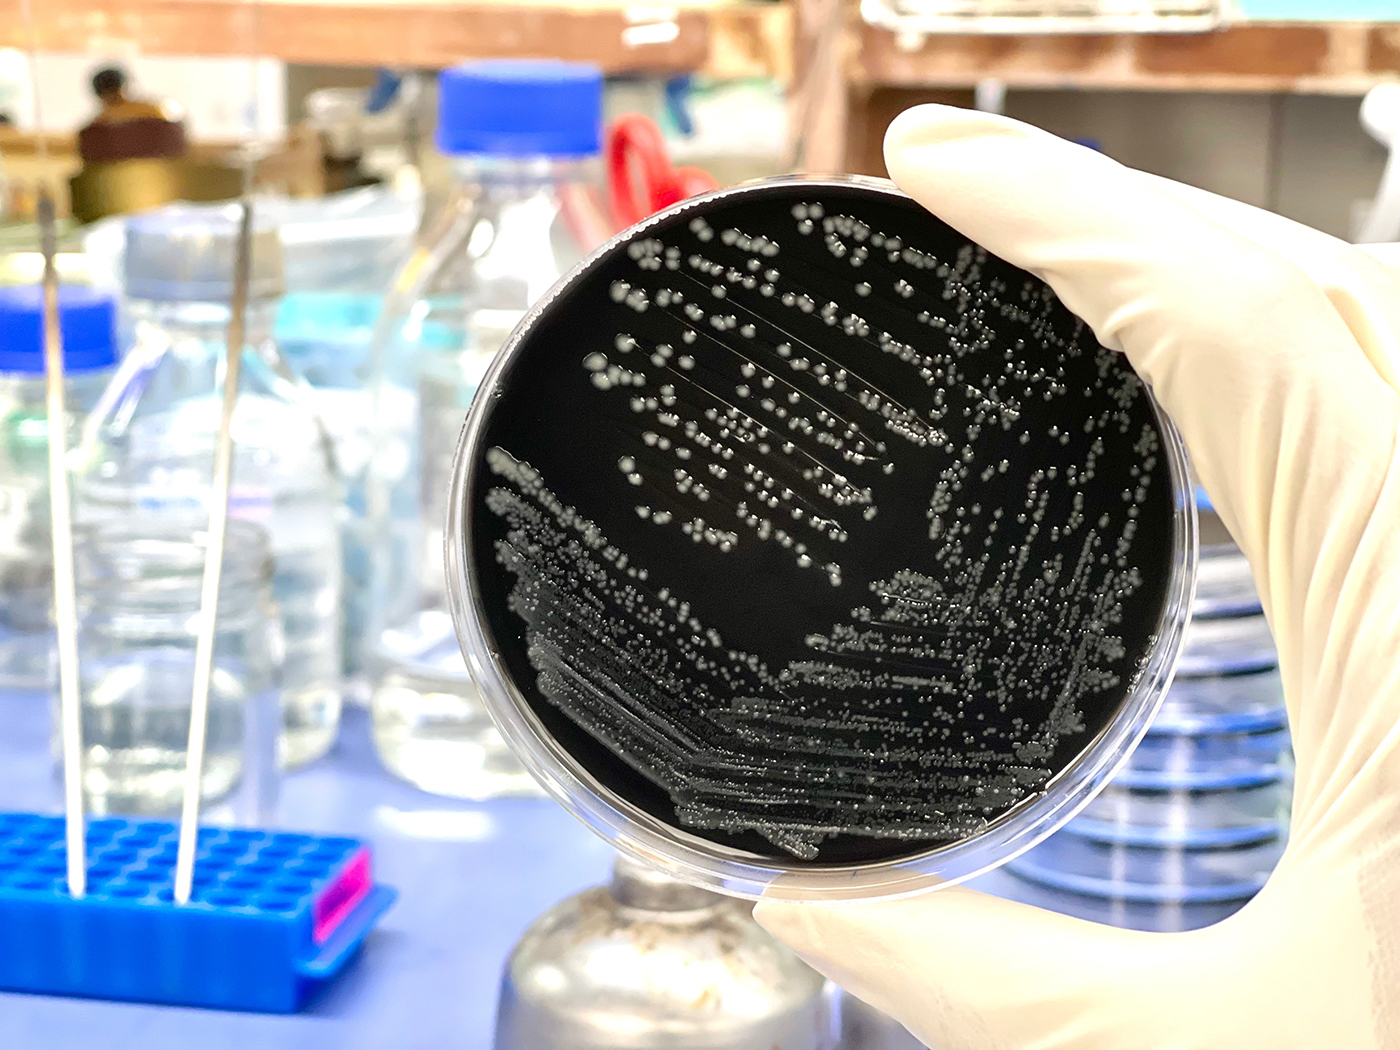
Campylobacter on a Petri Dish

Campylobacter Explained: History and Characteristics of the Bacterium
Campylobacter is a genus of bacteria that stands out as one of the leading causes of foodborne illnesses globally, affecting millions of people each year. Despite its prominence in public health, it does not share the same level of recognition as other notorious pathogens such as E. coli and Salmonella. This oversight is significant given the bacterium's considerable impact on human health, often resulting in severe gastrointestinal distress and, in some cases, leading to more serious complications. Campylobacter infections are typically acquired through the consumption of contaminated food, particularly undercooked poultry, unpasteurised milk, and untreated water, making it a critical concern for food safety and public health officials.
The genus Campylobacter comprises several species, with Campylobacter jejuni and Campylobacter coli being the most common culprits behind human infections. The ability of these bacteria to thrive in the intestines of animals, especially birds, and their resilience in the food supply chain underscores the importance of rigorous food handling and cooking practices.
This article delves into the detailed history of Campylobacter, tracing its discovery and the subsequent rise in recognition of its pathogenic role. Additionally, it will explore the bacterium's unique characteristics, such as its spiral shape and motility, which contribute to its virulence. Lastly, the article will discuss the public health implications of Campylobacter infections and outline strategies for prevention and control, highlighting the ongoing efforts to mitigate its impact on global health.
Classification
Campylobacter, a significant bacterial genus responsible for foodborne illnesses, is classified within a taxonomic framework that highlights its evolutionary relationships and distinct characteristics. This classification system in microbiology places Campylobacter in specific categories, each providing insight into its biology, ecology, and role in human health.
Kingdom: Bacteria
Bacteria constitute a vast domain of prokaryotic microorganisms, distinguished by their lack of a nucleus and membrane-bound organelles. They are among the earliest life forms on Earth and are essential for numerous ecological processes, including nutrient cycling, fermentation, and as agents of disease.
Phylum: Proteobacteria
Proteobacteria is a major phylum of Gram-negative bacteria, characterised by their diverse shapes, metabolic pathways, and ecological roles. Members of this phylum are known for their double-membrane cell envelope and include many important pathogens.
Class: Epsilonproteobacteria
Epsilonproteobacteria is a class within the Proteobacteria phylum, consisting mainly of bacteria that inhabit the gastrointestinal tracts of animals. This class is notable for its association with both beneficial and pathogenic interactions within the host.
Order: Campylobacterales
Campylobacterales is an order within the Epsilonproteobacteria class. Bacteria in this order are typically curved or spiral-shaped and Gram-negative. They are adapted to survive in the low-oxygen environments of animal intestines, and many are pathogenic to humans and other animals.
Family: Campylobacteraceae
Campylobacteraceae is the family within the Campylobacterales order, encompassing bacteria that are primarily microaerophilic, meaning they thrive in environments with lower oxygen levels than are present in the atmosphere. This family includes genera that are significant in both health and disease.
Genus: Campylobacter
The genus Campylobacter includes several species that are important human pathogens. These bacteria are spiral-shaped, motile, and Gram-negative. They are commonly found in the intestines of birds and mammals, and they play critical roles in foodborne illnesses.
Species: Campylobacter jejuni and Campylobacter coli
Campylobacter jejuni is the most well-known species within the Campylobacter genus, frequently causing gastrointestinal infections in humans. It is commonly associated with contaminated poultry, unpasteurised milk, and untreated water. Campylobacter coli is another significant species, similar in many ways to C. jejuni but less common. Both species can cause severe gastrointestinal symptoms, including diarrhoea, abdominal pain, fever, and nausea.
The classification of Campylobacter highlights its placement within the broader context of bacterial diversity and emphasises its unique characteristics that differentiate it from other microorganisms. This hierarchical system aids scientists in studying its biology, ecology, and interactions with hosts and environments, facilitating the development of strategies to prevent and control Campylobacter-related illnesses.
Strains
Campylobacter comprises several strains, each with distinct characteristics and impacts on human health. These strains can be broadly categorised into non-pathogenic and pathogenic types.
Non-pathogenic Strains: Non-pathogenic strains of Campylobacter are generally harmless and are often part of the natural microbiota in the gastrointestinal tracts of animals, particularly birds. These strains do not cause disease in their natural hosts and can play roles in maintaining gut health by participating in normal digestive processes.
Pathogenic Strains: Pathogenic strains of Campylobacter are responsible for a significant number of foodborne illnesses worldwide. Notable pathogenic strains include:
- Campylobacter jejuni:
Characteristics: C. jejuni is the most common cause of Campylobacter infections in humans. It is spiral-shaped, motile, and microaerophilic.
Pathogenic Mechanism: C. jejuni invades the intestinal mucosa, causing inflammation and diarrhoea. It produces toxins that contribute to its virulence.
Symptoms: Infections typically result in gastroenteritis, characterised by diarrhoea (often bloody), abdominal pain, fever, nausea, and vomiting.
Transmission: C. jejuni is commonly transmitted through the consumption of undercooked poultry, unpasteurised milk, and contaminated water. - Campylobacter coli:
Characteristics: C. coli is similar to C. jejuni in shape and growth requirements but is less prevalent.
Pathogenic Mechanism: Like C. jejuni, C. coli invades the intestinal lining and causes inflammation. It also produces toxins that damage the gut mucosa.
Symptoms: Infections caused by C. coli are similar to those caused by C. jejuni, including diarrhoea, abdominal pain, fever, and nausea.
Transmission: C. coli is also associated with contaminated food and water, particularly pork and poultry products. - Campylobacter upsaliensis:
Characteristics: C. upsaliensis is less commonly reported but can cause gastrointestinal illness.
Pathogenic Mechanism: This strain can adhere to and invade intestinal cells, leading to inflammation and diarrhea.
Symptoms: Infections typically present with diarrhea, abdominal pain, and fever.
Transmission: C. upsaliensis is often associated with contact with pets, particularly dogs and cats, which can carry the bacterium. - Campylobacter fetus:
Characteristics: C. fetus is distinct in that it can cause more severe systemic infections.
Pathogenic Mechanism: This strain can cross the intestinal barrier and enter the bloodstream, leading to bacteremia and systemic infections.
Symptoms: Infections can result in severe illness, including septicemia, particularly in immunocompromised individuals.
Transmission: C. fetus is typically transmitted through the consumption of contaminated meat and dairy products.
Understanding the different strains of Campylobacter and their mechanisms of pathogenicity is essential for developing targeted prevention and treatment strategies. Each strain's unique characteristics dictate its mode of transmission, the severity of the disease, and the most effective public health interventions to control its spread.
Pathogenesis
Pathogenic strains of Campylobacter have developed various sophisticated mechanisms to cause disease. These mechanisms enable the bacteria to colonise the host, evade the immune system, and damage host tissues, leading to a range of symptoms and illnesses.
Toxin Production: One of the primary mechanisms through which pathogenic Campylobacter strains cause disease is the production of toxins. These toxins disrupt the normal function of the host's cells and induce inflammation. For example, Campylobacter jejuni produces cytolethal distending toxin (CDT), which causes DNA damage in host cells. CDT arrests the cell cycle, leading to cell distention and death. This toxin contributes to the bacteria's ability to cause prolonged inflammation and damage to the intestinal lining.
Adhesion: Pathogenic Campylobacter strains possess various adhesins, which are molecules that enable them to adhere to the surfaces of host cells. This adhesion is crucial for colonisation and infection. For instance, Campylobacter jejuni uses several adhesins, such as CadF and JlpA, to bind to fibronectin and host cell membranes. This close adherence disrupts the normal function of the intestinal cells and facilitates the invasion of the host tissues. The bacteria's ability to adhere tightly to the intestinal epithelium is a key factor in their pathogenicity.
Invasion: Campylobacter strains can invade and multiply within host cells, a process that is crucial for their pathogenicity. They use a type IV secretion system to inject virulence factors into host cells, facilitating their uptake and intracellular survival. Once inside, Campylobacter can evade the host's immune response and replicate within the cells, causing significant damage. The invasion process disrupts the integrity of the intestinal epithelium, leading to symptoms such as diarrhea, abdominal pain, and inflammation.
Immune Evasion: Pathogenic Campylobacter strains have developed mechanisms to evade the host's immune system. They can modify their surface structures, such as lipooligosaccharides (LOS), to avoid recognition by the host's immune cells. Additionally, Campylobacter can resist the bactericidal activity of host antimicrobial peptides and produce enzymes that degrade host immune molecules. These strategies help Campylobacter to persist in the host and cause prolonged infections.
Inflammation: The interaction of Campylobacter with host cells triggers a strong inflammatory response. The bacteria stimulate the production of pro-inflammatory cytokines, such as interleukin-8 (IL-8), which attract immune cells to the site of infection. This inflammation contributes to the symptoms of Campylobacter infections, including diarrhea, fever, and abdominal pain. In severe cases, the inflammation can spread beyond the intestines, leading to complications such as Guillain-Barré syndrome, a neurological disorder.
These mechanisms highlight the complex interactions between pathogenic Campylobacter strains and their hosts. By producing toxins, adhering to and invading host cells, and evading the immune system, these bacteria can cause a wide range of diseases, from mild gastrointestinal disturbances to severe, life-threatening conditions. Understanding these pathogenic mechanisms is crucial for developing effective treatments and preventive strategies against Campylobacter infections.

Symptoms and Diseases
Infections caused by pathogenic Campylobacter strains can result in a variety of symptoms and lead to several diseases, each presenting distinct clinical features and potential complications. Recognising these symptoms is crucial for prompt diagnosis and effective treatment.
Campylobacteriosis (Gastroenteritis): The most common manifestation of Campylobacter infection is gastroenteritis, characterised by inflammation of the stomach and intestines. Symptoms typically include diarrhea, which can be watery or bloody, abdominal cramps, nausea, and fever. The severity and duration of symptoms vary, but most cases of campylobacteriosis are self-limiting and resolve within a week without specific treatment. However, in some cases, particularly in young children, elderly individuals, or immunocompromised patients, the infection may lead to more severe complications.
Guillain-Barré Syndrome (GBS): Guillain-Barré Syndrome is a rare but serious autoimmune disorder that can develop following a Campylobacter infection, particularly Campylobacter jejuni. In GBS, the immune system mistakenly attacks the peripheral nerves, leading to muscle weakness, tingling sensations, and in severe cases, paralysis. Symptoms usually begin in the legs and can progress to affect the arms and upper body. Prompt medical treatment is essential to manage symptoms and prevent complications.
Reactive Arthritis: Reactive arthritis, also known as Reiter's syndrome, can occur as a complication of Campylobacter infection. It is characterised by joint pain, swelling, and stiffness, often affecting the knees, ankles, and feet. Reactive arthritis typically develops several weeks after the initial infection and may be accompanied by inflammation of the eyes (conjunctivitis) and urinary tract symptoms.
Bacteremia and Septicemia: In rare cases, Campylobacter can enter the bloodstream (bacteremia) and cause systemic infection (septicemia). This condition is more likely to occur in individuals with weakened immune systems or underlying health conditions. Symptoms of bacteremia and septicemia include fever, chills, rapid breathing, and confusion. Immediate medical attention and treatment with antibiotics are necessary to prevent severe complications.
Post-Infectious Irritable Bowel Syndrome (PI-IBS): Some individuals may develop post-infectious irritable bowel syndrome (PI-IBS) following a Campylobacter infection. PI-IBS is characterised by persistent abdominal pain, bloating, and altered bowel habits, such as diarrhea or constipation. The exact mechanisms leading to PI-IBS are not fully understood but may involve ongoing inflammation and changes in gut motility following the initial infection.
Miscellaneous Symptoms: Campylobacter infections can also lead to symptoms such as headache, muscle pain, and fatigue, especially during the acute phase of illness. These symptoms are typically non-specific but can contribute to the overall discomfort experienced by individuals with campylobacteriosis.
Understanding the diverse range of symptoms and diseases associated with Campylobacter infections is essential for healthcare providers to deliver appropriate care and management. Public awareness of these symptoms can empower individuals to seek medical attention promptly, aiding in early diagnosis and reducing the risk of complications associated with severe Campylobacter-related illnesses.
Transmission
Campylobacter is a bacterium that can be transmitted through various routes, primarily affecting the gastrointestinal system. Understanding these modes of transmission is crucial for preventing infections and managing public health risks.
Consumption of Contaminated Food and Water: The most common mode of transmission for Campylobacter is through the consumption of food or water contaminated with the bacterium. Campylobacter can contaminate poultry, meat (especially poultry and unpasteurised milk), and untreated water sources through contact with infected animal faeces or during processing. Improper food handling, inadequate cooking (especially of poultry), and consumption of raw or undercooked foods increase the risk of infection. Proper cooking and safe food handling practices, including thorough washing of fruits and vegetables, are essential preventive measures.
Direct Contact with Infected Animals: Campylobacter can be transmitted through direct contact with infected animals, particularly poultry, which are known reservoirs of the bacterium. Handling of live animals, especially in settings such as farms, petting zoos, and veterinary clinics, can lead to transmission through contact with faeces or contaminated surfaces. Proper hygiene practices, including handwashing after handling animals, are critical to prevent transmission.
Person-to-Person Contact: Although less common, Campylobacter can spread through direct person-to-person contact, particularly in households and institutional settings with poor hygiene practices. This can occur through faecal-oral transmission, where contaminated hands transfer the bacterium from one person to another. Ensuring proper handwashing, especially after using the toilet and before handling food, is essential to reduce the risk of transmission.
Contaminated Environments: Campylobacter can persist in environments contaminated with animal faeces, such as agricultural settings and water sources. Contaminated surfaces, utensils, and equipment can serve as reservoirs for the bacterium and contribute to its transmission. Effective sanitation practices, including regular cleaning and disinfection of surfaces, are necessary to minimise environmental contamination and reduce the risk of infection.
Recreational Water Activities: Campylobacter can occasionally be transmitted through recreational water sources contaminated with animal faeces or untreated sewage. Swallowing water while swimming in lakes, ponds, or improperly treated swimming pools can lead to infection. Avoiding ingestion of untreated water and practicing good hygiene, such as showering after swimming, can help prevent waterborne transmission.
Understanding and Mitigating Risks: Awareness of these transmission routes is crucial for implementing preventive measures against Campylobacter infections. Public education campaigns emphasising safe food handling, proper handwashing, and avoiding consumption of raw or undercooked foods are essential. Additionally, regulatory measures to ensure food safety and sanitation standards in agricultural and food processing industries play a critical role in reducing the incidence of Campylobacter infections and protecting public health.
Diagnosis
Diagnosing a Campylobacter infection involves employing various laboratory techniques to accurately identify the bacterium responsible for the illness. Timely and precise diagnosis is essential for effective treatment and management of the infection.
Stool Culture: Stool culture is a primary method for diagnosing Campylobacter infections. A faecal sample from the patient is collected and cultured on selective media that promote the growth of Campylobacter species while inhibiting other bacteria. Campylobacter colonies are identified based on their characteristic morphology, such as curved or spiral-shaped rods. Biochemical tests, such as oxidase and catalase tests, further confirm the presence of Campylobacter. Stool culture remains a reliable method despite Campylobacter's fastidious nature, which can complicate isolation.
PCR (Polymerase Chain Reaction): PCR is a molecular technique used to detect specific DNA sequences of Campylobacter, enhancing diagnostic sensitivity and specificity. This method amplifies target genes unique to Campylobacter species, facilitating rapid and accurate identification even in low concentrations. PCR is particularly useful for detecting Campylobacter species that may be present in low numbers or for distinguishing between different species and strains.
Serology: Serological tests can detect antibodies against Campylobacter in the patient's blood serum. These tests are useful for confirming recent or past infections, especially when stool cultures are negative or unavailable. Serological methods are also valuable for epidemiological studies and outbreak investigations, providing insights into the prevalence of Campylobacter infections within populations.
Antigen Detection: Enzyme immunoassays (EIAs) or enzyme-linked immunosorbent assays (ELISAs) can detect Campylobacter antigens, such as lipopolysaccharides (LPS), in stool samples. These assays are rapid and can provide results within hours, aiding in early diagnosis and treatment initiation. Antigen detection tests are particularly beneficial in clinical settings requiring quick turnaround times, such as hospital emergency departments.
Microscopy: Microscopic examination of faecal samples can occasionally reveal the presence of Campylobacter cells, although this method is less sensitive compared to culture and molecular techniques. Direct visualisation of characteristic curved or spiral-shaped rods in stained faecal smears can provide preliminary evidence of Campylobacter infection.
Combining Diagnostic Approaches: A comprehensive diagnostic approach often combines stool culture as the gold standard with PCR for rapid identification and confirmation of Campylobacter species. Serotyping and antigen detection further enhance diagnostic accuracy, especially in outbreak investigations and monitoring antibiotic resistance patterns.
Accurate and prompt diagnosis of Campylobacter infections is crucial for guiding appropriate treatment, preventing complications, and implementing public health measures to control the spread of infection. Healthcare providers rely on these diagnostic methods to ensure effective patient care and to mitigate the impact of Campylobacter-related illnesses on public health.
Treatment
Managing Campylobacter infections involves several strategies depending on the severity of symptoms and the specific strain of bacteria involved. The goals of treatment are to alleviate symptoms, prevent complications, and support the body's healing process.
Hydration: Ensuring adequate hydration is crucial in managing Campylobacter infections, particularly to counteract fluid loss from diarrhoea. Patients are encouraged to drink plenty of fluids, such as water, oral rehydration solutions (ORS), and electrolyte-rich drinks. ORS are especially beneficial as they help restore lost fluids and electrolytes, which are essential for maintaining hydration and supporting bodily functions. In severe cases where oral intake is insufficient due to vomiting or profuse diarrhoea, intravenous fluids may be necessary to restore hydration and electrolyte balance.
Antibiotics: The use of antibiotics for treating Campylobacter infections depends on the severity of symptoms and the risk factors involved. In many cases, especially uncomplicated infections, antibiotics are not routinely recommended because symptoms often resolve on their own within a few days to a week. However, for severe infections or in vulnerable populations, such as young children or immunocompromised individuals, antibiotics like azithromycin or fluoroquinolones may be prescribed to shorten the duration of illness and reduce the severity of symptoms. Resistance patterns and local guidelines play a crucial role in antibiotic selection.
Supportive Care: Supportive care aims to manage symptoms and promote recovery. Resting and allowing the body to recover are essential. Maintaining electrolyte balance is critical, particularly in cases with prolonged diarrhoea. Oral electrolyte solutions or intravenous supplements may be used to prevent dehydration and electrolyte imbalances. Antidiarrheal medications are generally avoided as they can prolong the duration of infection by delaying the elimination of Campylobacter from the intestines.
Nutritional Support: In severe cases, especially in vulnerable populations such as young children or the elderly, nutritional support may be necessary to ensure adequate intake of nutrients. A bland diet, avoiding spicy foods and dairy products, can help manage gastrointestinal symptoms and support recovery.
Consultation and Monitoring: Healthcare providers monitor patients closely to assess the progression of symptoms and determine the need for additional interventions. Follow-up consultations may be necessary to ensure complete recovery and address any lingering symptoms or complications.
Preventive Measures: Preventing Campylobacter infections involves practicing good hygiene, particularly thorough handwashing with soap and water after handling raw poultry or animal faeces, and ensuring food safety by cooking poultry thoroughly and avoiding unpasteurised milk products. Public health measures such as surveillance and outbreak investigation are critical for identifying sources of infection and implementing targeted interventions.
Effective management of Campylobacter infections requires a comprehensive approach that addresses symptoms, supports hydration and nutrition, and prevents complications. Tailored treatment plans based on individual patient factors and the specific characteristics of the infecting strain are essential for achieving optimal outcomes and reducing the impact of the infection on patient health.
Prevention
Preventing Campylobacter infections involves adopting several key practices focused on food safety, personal hygiene, and ensuring the cleanliness of water sources. These measures are essential for minimising the risk of both individual infections and community-wide outbreaks.
Safe Food Handling: Properly handling and preparing food is crucial to prevent Campylobacter infections. Ensure that poultry, particularly chicken and turkey, is cooked thoroughly to an internal temperature of at least 165°F (74°C) to kill any bacteria present. Use a food thermometer to verify the temperature. Avoid consuming undercooked poultry or dishes containing raw or undercooked eggs. Separate raw meat, poultry, and seafood from other foods during storage and preparation to prevent cross-contamination. Wash hands, cutting boards, utensils, and countertops thoroughly with soap and hot water after handling raw foods.
Good Hygiene Practices: Maintaining excellent personal hygiene habits is essential in preventing the spread of Campylobacter bacteria. Wash hands thoroughly with soap and water for at least 20 seconds:
- Before preparing or eating food
- After handling raw meat, poultry, or seafood
- After using the toilet or changing diapers
- After touching animals or their environment
If soap and water are not available, use an alcohol-based hand sanitiser with at least 60% alcohol. Ensure thorough cleaning of all parts of the hands, including under nails and between fingers, to remove bacteria effectively.
Safe Water Sources: Access to clean and safe drinking water is critical in preventing waterborne infections, including those caused by Campylobacter. Drink water from treated and tested sources whenever possible. If the safety of the water supply is uncertain, boil water vigorously for at least one minute to kill bacteria and parasites that may be present. Use water filters certified to remove bacteria or disinfect water with chlorine or iodine tablets when camping or traveling to areas with potentially unsafe water sources. Avoid swallowing water from untreated lakes, rivers, or streams, especially in recreational settings.
Environmental and Community Measures: Community-wide efforts are vital in preventing Campylobacter infections. Implement measures to ensure food safety in restaurants, cafeterias, and other food service establishments, including rigorous hygiene practices among food handlers and regular cleaning and sanitation of food contact surfaces. Public education campaigns should promote awareness of Campylobacter and emphasise the importance of hygiene and safe food handling practices at home and in public settings.
By following these preventive measures consistently, individuals and communities can significantly reduce the risk of Campylobacter infections. Early adoption of these practices, coupled with ongoing education and public health initiatives, plays a critical role in protecting public health and preventing outbreaks.

Research
Campylobacter is a focal point of ongoing research and public health initiatives due to its significant impact on food safety and public health. This bacterium is a leading cause of bacterial gastroenteritis worldwide, emphasising the importance of understanding its pathogenic mechanisms and developing effective control measures.
Campylobacteriosis Outbreak Investigation: Researchers investigate outbreaks of Campylobacter infections to identify sources and transmission routes. This includes tracing contaminated food products, water sources, and environmental exposures that contribute to outbreaks. Understanding these factors helps inform preventive strategies and improve food safety regulations.
Pathogenic Mechanisms: Research aims to uncover the specific virulence factors and mechanisms that enable Campylobacter to cause disease. This includes studying its ability to adhere to intestinal epithelial cells, invade tissues, and evade the host immune response. By elucidating these mechanisms, researchers seek to develop targeted therapies and vaccines to combat infections effectively.
Antibiotic Resistance: The emergence of antibiotic-resistant Campylobacter strains presents a growing public health concern. Research investigates the genetic basis of resistance and the mechanisms by which Campylobacter acquires and spreads resistance genes. Strategies are explored to mitigate resistance through prudent antibiotic use, alternative treatments, and development of new antimicrobial agents.
Genomic Studies: Campylobacter's genome is studied to understand its genetic diversity, evolution, and adaptation to different environments. Comparative genomics helps identify genes associated with virulence, antibiotic resistance, and survival mechanisms. This information aids in tracking outbreaks, predicting pathogen behavior, and developing diagnostic tools.
Public Health Efforts
Surveillance and Reporting: Public health agencies conduct surveillance to monitor Campylobacter infections and detect outbreaks promptly. Data collected from surveillance systems inform public health responses, including implementing control measures and issuing alerts to healthcare providers and the public.
Public Education Campaigns: Educational initiatives raise awareness about Campylobacteriosis, emphasising safe food handling practices, proper hygiene, and the risks associated with consuming undercooked poultry and contaminated water. These campaigns promote behaviours that reduce transmission and prevent infection.
Regulatory Measures: Regulations and guidelines are established based on research findings to improve food safety standards and prevent Campylobacter contamination in food production and processing environments. This includes implementing hygiene practices among food handlers, ensuring sanitary conditions in poultry farms, and enhancing monitoring of water quality.
Biotechnological Applications
Campylobacter as a Model Organism: Beyond its pathogenicity, Campylobacter serves as a model organism in microbiology and biotechnology. Its genetic tractability and physiological characteristics make it valuable for studying fundamental biological processes, such as metabolism and gene regulation. Research using Campylobacter contributes to advancements in biotechnological applications, including vaccine development and bioremediation.
Major Campylobacter Outbreaks in the UK
Campylobacteriosis outbreaks in the UK have underscored significant public health challenges, emphasising the importance of food safety measures and surveillance systems to prevent widespread illness and fatalities.
Plymouth Outbreak (2005)
- Pathogen: Campylobacter jejuni
- Source: Contaminated water supply affecting multiple households in Plymouth.
- Impact: Approximately 1,000 cases reported, with severe gastrointestinal symptoms.
- Response: Prompted investigation into water treatment processes and public health campaigns to educate residents on safe water consumption practices.
Southampton Outbreak (2011)
- Pathogen: Campylobacter jejuni
- Source: Consumption of undercooked chicken at a local restaurant chain.
- Impact: Over 400 confirmed cases, leading to widespread community concern.
- Response: Increased scrutiny on restaurant food handling practices, enforcement of cooking guidelines for poultry, and public education initiatives on safe food preparation.
West Midlands Outbreak (2014)
- Pathogen: Campylobacter jejuni
- Source: Cross-contamination during food preparation in catering services.
- Impact: Hundreds of cases reported across catering events, affecting both attendees and staff.
- Response: Implementation of stricter hygiene protocols for catering services, including training programs for food handlers and enhanced monitoring by public health authorities.
North Yorkshire Outbreak (2018)
- Pathogen: Campylobacter jejuni
- Source: Consumption of unpasteurised milk from a local dairy farm.
- Impact: Dozens of confirmed cases linked to raw milk consumption.
- Response: Heightened regulations on the sale and distribution of raw milk, with increased emphasis on pasteurisation to reduce bacterial contamination risks.
Multi-Country Outbreak Linked to Chicken (2020)
- Pathogen: Campylobacter jejuni
- Source: Contaminated chicken products distributed across several European countries.
- Impact: Hundreds of cases reported across the UK and Europe, leading to severe gastroenteritis and hospitalisations.
- Response: Collaborative efforts between national health agencies and food safety authorities to trace contaminated products, recall affected batches, and reinforce poultry processing standards.
These outbreaks highlight the persistent challenges posed by Campylobacter infections in the UK. Efforts to mitigate future outbreaks necessitate stringent food safety practices, robust surveillance systems, and continuous public education on safe food handling and consumption. By addressing these factors, authorities aim to reduce the incidence of Campylobacteriosis and safeguard public health effectively.
Ongoing Surveillance and Response for Campylobacter in the UK
Campylobacteriosis remains a focal point of surveillance and response efforts in the UK, emphasising proactive measures to prevent infections and manage outbreaks effectively.
Enhanced Food Safety Regulations:
- Continuous Updates: Regular revision of food safety regulations ensures adherence to stringent standards across food production, processing, and distribution sectors.
- Comprehensive Guidelines: Clear guidelines promote safe handling of poultry, emphasising thorough cooking and avoiding cross-contamination to mitigate Campylobacter transmission.
Public Health Campaigns:
- Educational Initiatives: Public awareness campaigns educate consumers on safe food preparation practices, including proper cooking temperatures and hygiene measures.
- Industry Training: Training programs for food handlers underscore the importance of hygiene protocols to prevent Campylobacter contamination in food establishments.
Rapid Response Protocols:
- Collaborative Efforts: Coordination among health agencies, including the UK Health Security Agency and the Food Standards Agency (FSA), ensures swift identification and containment of Campylobacter outbreaks.
- Effective Communication: Timely dissemination of outbreak information to healthcare providers, the food industry, and the general public facilitates prompt response measures and minimises further spread.
Research and Monitoring:
- Pathogen Surveillance: Continuous surveillance monitors Campylobacter prevalence trends, identifying high-risk sources and transmission routes.
- Technological Advancements: Research advancements focus on innovative detection methods and interventions to enhance Campylobacter control, including genetic analysis and antimicrobial resistance studies.
The UK's robust surveillance and response framework for Campylobacteriosis integrates regulatory updates, public education campaigns, rapid response protocols, and ongoing research initiatives. These comprehensive efforts aim to reduce Campylobacter infections, safeguard public health, and strengthen the resilience of the food safety system against emerging challenges. By fostering collaboration between stakeholders and leveraging scientific innovations, the UK continues to adapt and enhance strategies for effective Campylobacter management and prevention.
Summary
Campylobacteriosis encompasses a spectrum of strains, some benign and others pathogenic, highlighting its dual role in gut health and disease. Non-pathogenic strains are vital members of the gut microbiota, aiding digestion and bolstering immunity by competing with harmful bacteria. They're integral to synthesising essential nutrients like vitamin K.
However, pathogenic strains like Campylobacter jejuni pose health risks, causing various illnesses ranging from mild gastroenteritis to severe complications such as Guillain-Barré syndrome (GBS), which can lead to paralysis. These strains possess virulence factors enabling them to colonise the intestinal lining, produce toxins, and trigger inflammatory responses, culminating in symptoms spanning from mild diarrhea to severe abdominal cramps and fever.
Understanding Campylobacter strains is pivotal for effective prevention and treatment. Each strain varies in virulence and transmission routes—commonly via consumption of undercooked poultry or contaminated water, and less frequently through direct contact with infected animals or persons. Research illuminates strain-specific characteristics, informing targeted public health measures like stringent food safety regulations and enhanced hygiene practices. Rapid diagnosis hinges on recognising distinct symptoms, expediting appropriate treatment and mitigating complications.
Preventive strategies are paramount in curtailing Campylobacter infections. Emphasising meticulous food handling—thoroughly cooking poultry and avoiding cross-contamination—augments safety. Rigorous hygiene, particularly handwashing after handling raw meat or using the bathroom, bolsters protection. Safeguarding water sources from contamination also reduces risks. Public education campaigns heighten awareness of Campylobacter risks and foster adherence to preventative practices.
In essence, comprehensive knowledge of Campylobacter strains, their transmission dynamics, and proactive prevention measures are pivotal in managing its impact on public health. This approach ensures the mitigation of pathogenic risks while preserving the beneficial roles of non-pathogenic strains in maintaining gut health and overall well-being.
Further Reading
Centers for Disease Control and Prevention (CDC) - Campylobacter (Campylobacteriosis)
CDC Campylobacter
This resource provides comprehensive information on Campylobacter, including symptoms, treatment, and prevention.
World Health Organization (WHO) - Campylobacter
WHO Campylobacter
The WHO fact sheet offers a global perspective on the impact of Campylobacter and its public health significance.
Food and Drug Administration (FDA) - Bad Bug Book: Foodborne Pathogenic Microorganisms and Natural Toxins Handbook
FDA Bad Bug Book
This handbook includes detailed information on Campylobacter and other foodborne pathogens.
National Institute of Allergy and Infectious Diseases (NIAID) - Campylobacter
NIAID Campylobacter
NIAID provides research-based information on Campylobacter, focusing on its causes and ongoing studies.
European Food Safety Authority (EFSA) - Campylobacter
EFSA Campylobacter
EFSA’s website contains information on Campylobacter, including risk assessments and scientific opinions.
Public Health England (PHE) – Campylobacter Information
PHE Campylobacter Information
This information by Public Health England provides an overview of Campylobacter, its symptoms, and preventive measures.
Journal of Clinical Microbiology - Articles on Campylobacter
Journal of Clinical Microbiology
Search for Campylobacter in this journal for peer-reviewed research articles on the bacterium.
National Library of Medicine - Campylobacter Infections
MedlinePlus Campylobacter Infections
MedlinePlus offers a patient-friendly overview of Campylobacter infections, including causes, symptoms, and treatment.
Campylobacter: Features, Detection, and Prevention of Foodborne Disease
Nachamkin, I., Szymanski, C. M., Blaser, M. J. (Eds.) (2008). Campylobacter. ASM Press.
This book provides in-depth coverage of Campylobacter, including its microbiology, clinical aspects, and preventive measures.
Book on Amazon
What Next?
🔗 Follow us on Social Media, here is our LINK TREE
✉️ See how our additive technology can benefit your business by CONTACTING US
🦠 Find out more about Biomaster Antimicrobial Technology HERE
🎥 Watch our video on how Biomaster works WATCH NOW
📰 Subscribe to our Newsletter - SUBSCRIBE
← Back to blog